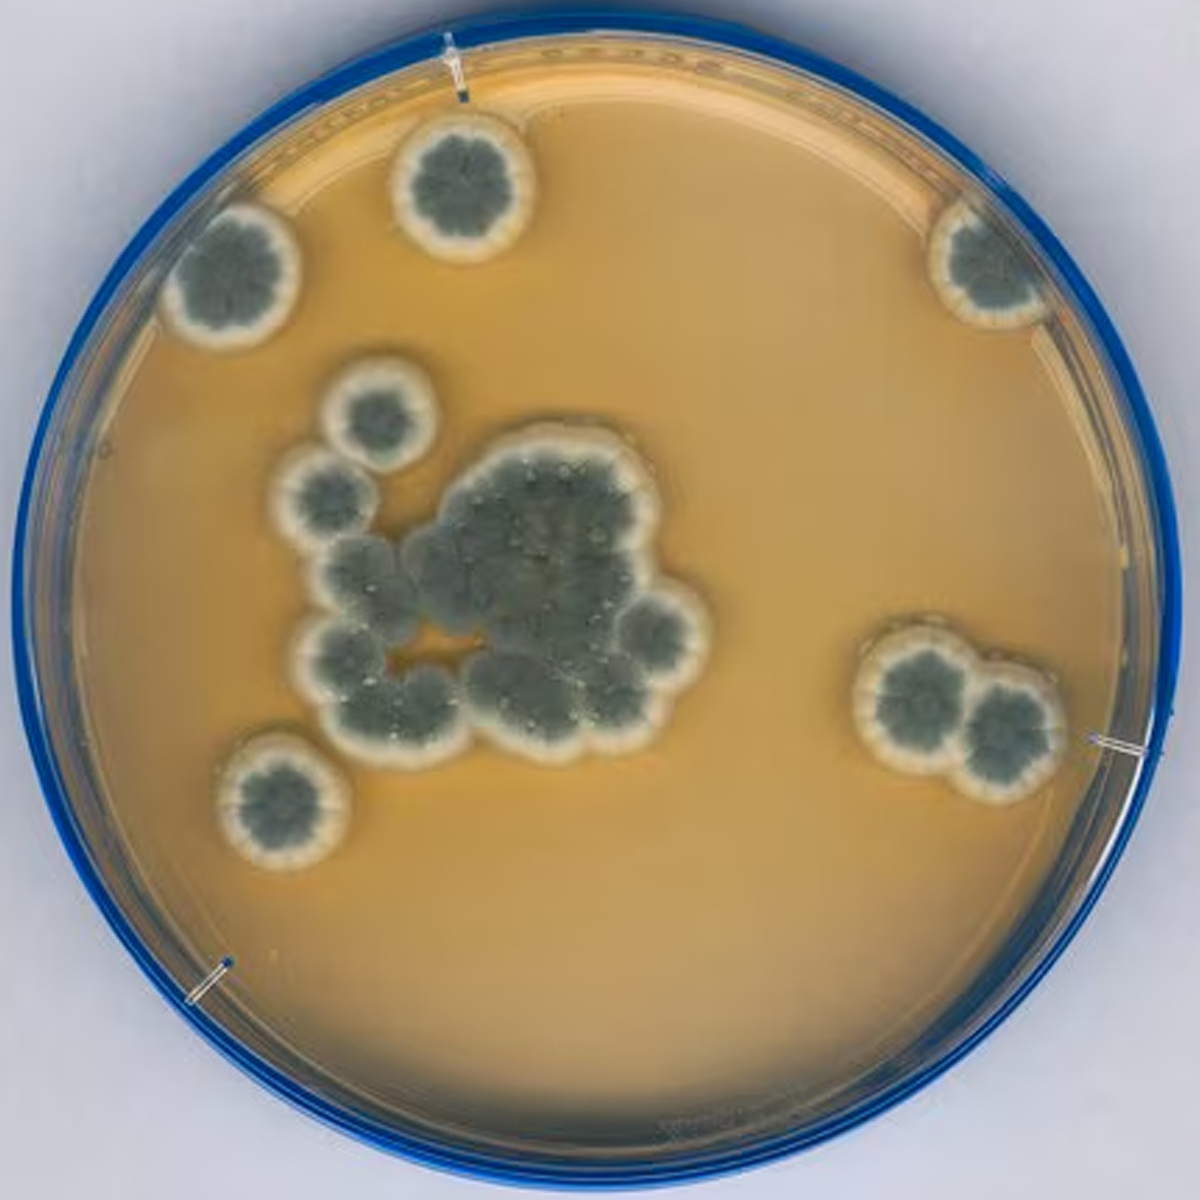

1
/
/
1
SKU-koodi:1460050020
Merck Life Science
ICR laskeumamalja SDA LTHTh
ICR laskeumamalja SDA LTHTh
Tilaustuote tai tilapäisesti loppu varastosta.
Tuotteen kuvaus
Tuotteen kuvaus
Sodium thiosulphate, Tween®, Histidine, Lecithin, lid, ICR: non lockable 30 mL, plate diam. 90 mm, sterile; irradiated, triple packed of 20 or 120 plates, suitable for air monitoring
Lisätietoja
Lisätietoja
Lataukset / käyttöohjeet
Lataukset / käyttöohjeet